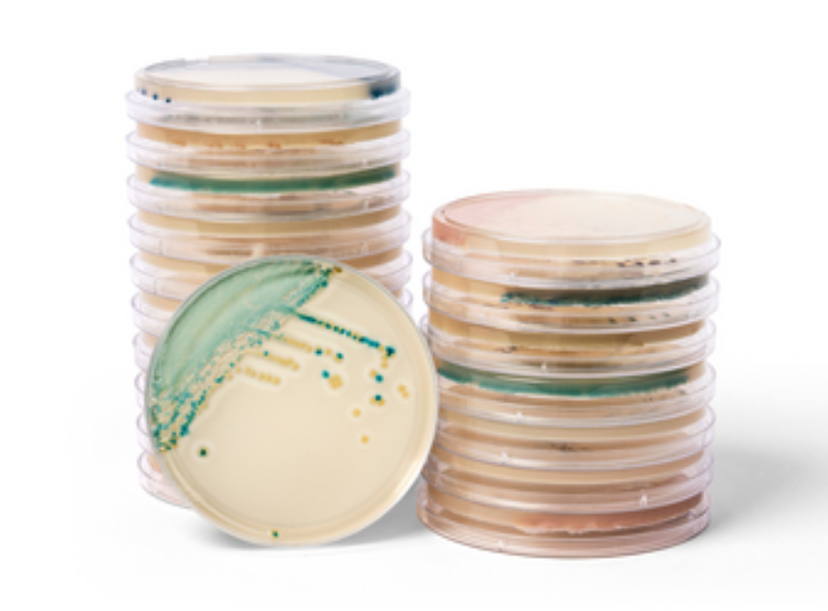
Thermo Scientific™ Brilliance™ Candida 2 Agar and Spectra™ Candida Agar, new color-based (chromogenic) culture media

New color-based (chromogenic) culture media to help detect Candida infections faster
Brilliance Candida 2 Agar and Spectra Candida Agar support earlier detection, faster outbreak response and more informed treatment decisions in healthcare settings*
12 Mar 2026Product news
Thermo Scientific™ Brilliance™ Candida 2 Agar and Spectra™ Candida Agar, new color-based (chromogenic) culture media
Thermo Fisher Scientific has launched the Thermo Scientific™ Brilliance™ Candida 2 Agar and Spectra™ Candida Agar**, new color-based (chromogenic) culture media to help laboratories quickly detect and differentiate clinically important Candida species — including Candida auris.
Invasive fungal infections are an increasing challenge for healthcare systems worldwide, driven in part by the rapid spread of Candida auris. This pathogen is often resistant to multiple antifungal treatments, can spread quickly in healthcare settings and is associated with serious illness and high mortality rates.
As screening and surveillance efforts expand, clinical microbiology laboratories need faster, reliable tools to identify infections and support infection prevention and control1.
Thermo Scientific Brilliance Candida 2 Agar and Spectra Candida Agar are designed to address this need by enabling clear, species-specific chromogenic reactions directly from primary culture. This allows laboratories to visually differentiate the most clinically relevant Candida species, including direct identification of Candida auris, with shorter incubation times compared to conventional culture methods.
Earlier intervention can support timely clinical decisions, appropriate antifungal therapy, and rapid infection control measures during routine screening and outbreak investigations.
By combining broad species differentiation with practical incubation and storage conditions, Thermo Fisher Scientific’s Brilliance Candida 2 Agar and Spectra Candida Agar support laboratories of all sizes in meeting increasing testing demands while maintaining high standards of quality and consistency. This solution strengthens global efforts in antimicrobial resistance surveillance, outbreak preparedness, infection prevention, and Candida diagnostics workflow.
“As new pathogens emerge that threaten patients and healthcare settings, it’s increasingly important that healthcare providers have effective screening strategies that don’t add complexity to routine laboratory workflows,” said Chris Armstrong, president of the microbiology business at Thermo Fisher Scientific.
“This new media delivers clear visual differentiation and faster results, helping laboratories respond confidently to emerging fungal threats and strengthening frontline defences against antimicrobial resistance, while maintaining efficiency and consistency,” he added.
*Compared to conventional culture media methods.
** Thermo Scientific Brilliance Candida 2 Agar is available for purchase in Europe, while Spectra Candida Agar is available in the United States. The solutions offer the same level of performance and are tailored to meet the laboratory requirements of each region.
References
1. Cornely, Oliver A et al. Global guideline for the diagnosis and management of candidiasis: an initiative of the ECMM in cooperation with ISHAM and ASM. The Lancet Infectious Diseases, Volume 25, Issue 5, e280-e293.